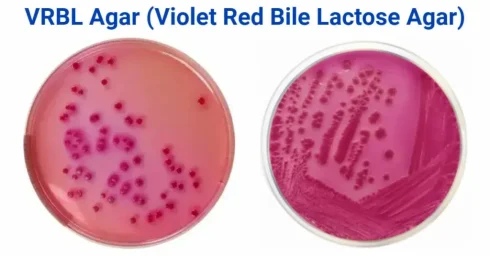
آگار VRBL چیست؟
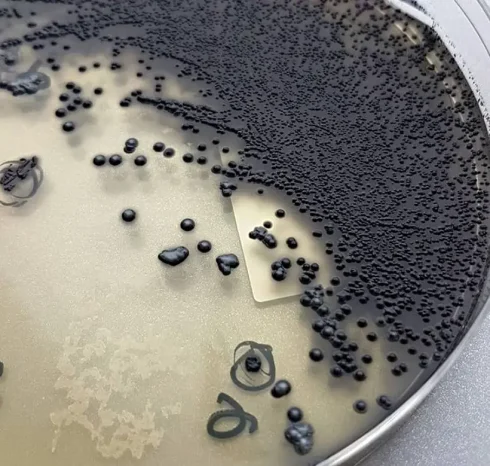
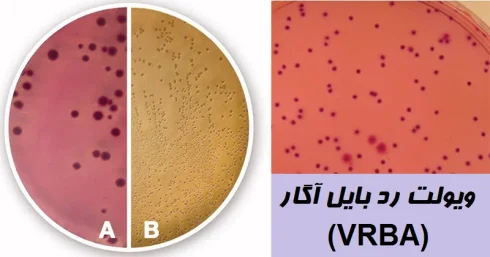
محیط کشت VRBA
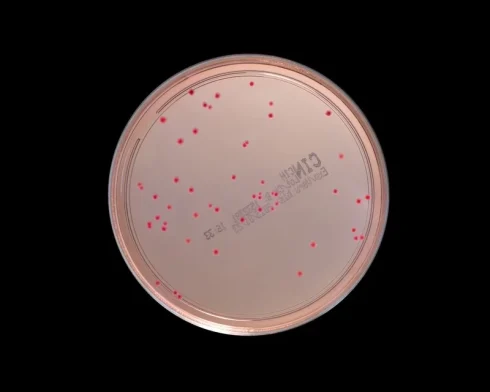
محیط کشت CIN چیست؟
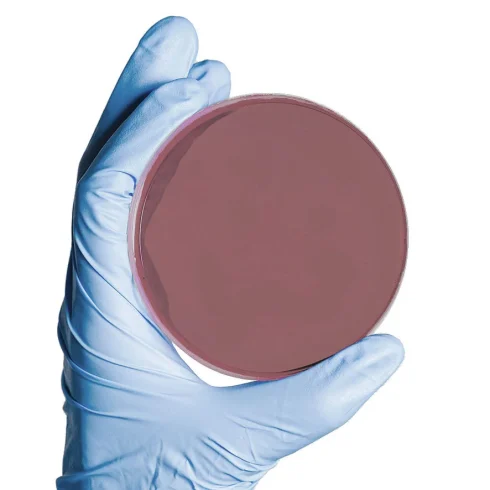
مارتین لوئیس آگار

آرشیو دسته بندی: ابزار و وسایل آزمایشگاهی شامل، محلول ها کیت ها
محیطهای کشت اختصاصی جنین شناسی و IVF
مقدمهای بر محیطهای کشت اختصاصی جنین شناسی و IVF در جنین شناسی، محیط کشت تخصصی[بیشتر بخوانید]
آگار VRBL چیست؟ ترکیبات، اصول، طرز تهیه و تفسیر نتایج
آگار VRBL چیست؟ آگار VRBL (آگار لاکتوز صفراوی قرمز بنفش) یا Violet red bile lactose[بیشتر بخوانید]
انواع رنگآمیزی مورد استفاده در میکروبیولوژی
مقدمهای بر انواع رنگآمیزی مورد استفاده در میکروبیولوژی انواع مختلفی از رنگآمیزی وجود دارد که[بیشتر بخوانید]
4 دیدگاه
بافر TBE چیست؟ نحوه آمادهسازی بافر TBE
چگونه بافر TBE (Tris Borate EDTA) را تهیه کنیم؟ TBE که به عنوان Tris Borate[بیشتر بخوانید]
لوله خونگیری و اهمیت کدگذاری در رنگها
لوله خونگیری و رنگ های مختلف آن آزمایشهای مختلف و سنجش بیوشیمیایی به انواع مختلفی[بیشتر بخوانید]
پیپت چند کاناله (Multichannel Pipette): اجزا و کالیبراسیون
مقدمهای بر پیپت چند کاناله نمونه برداری با پیپت برای جابجایی مایعات بدون آلوده شدن،[بیشتر بخوانید]
بمباران ریز پرتابه در انتقال ژن: اساس، مراحل، کاربرد
مقدمهای بر بمباران ریز پرتابه (Microprojectile Bombardment) در انتقال ژن بمباران ریز پرتابه یکی از[بیشتر بخوانید]
تجهیزات مورد استفاده در آزمایشگاه میکروبیولوژی
آزمایشگاه میکروبیولوژی با کشت و شناسایی میکروارگانیسمهایی مانند باکتریها، قارچها، ویروسها و غیره سر و[بیشتر بخوانید]
آلکالین پپتون واتر (Alkaline Peptone Water): ترکیب، اصول، روش آمادهسازی، نتایج، موارد استفاده
مقدمهای بر محیط کشت آلکالین پپتون واتر آلکالین پپتون واتر یک محیط کشت براث (Broth)[بیشتر بخوانید]
بورسکوپ در زیست شناسی: تعریف، کاربرد، محدودیت
مقدمهای بر بورسکوپ در زیست شناسی بررسی اعضای بدن انسان ضروری است و خوشبختانه، با[بیشتر بخوانید]
آگار تینسدال (Tinsdale): ترکیب، آمادهسازی و موارد استفاده
مقدمهای بر آگار تینسدال محیط پایه آگار تینسدال توسط Tinsdale برای جداسازی و افتراق انتخابی[بیشتر بخوانید]
رزونانس اسپین الکترون (ESR): اصول، ابزار، کاربردها
رزونانس اسپین الکترون (ESR) چیست؟ رزونانس اسپین الکترون (ESR) که با نامهای رزونانس مغناطیسی الکترون[بیشتر بخوانید]
2 دیدگاه
محیط انتقال ویروس (VTM): اصول، آمادهسازی، کاربرد و محدودیت
تعریف محیط انتقال ویروس (VTM) محیط انتقال ویروس (VTM) یک ماده مغذی است که برای[بیشتر بخوانید]
محیط کشت RCM: ترکیبات، آماده سازی، تفسیر و کاربردها
مقدمهای بر محیط کشت RCM محیط گوشت پخته شده رابرتسون (RCM) برای کشت میکروارگانیسمهای هوازی،[بیشتر بخوانید]
فولدسکوپ چیست؟ آشنایی با میکروسکوپ کاغذی و ویژگی های آن
مقدمهای بر فولدسکوپ یا میکروسکوپ کاغذی فولدسکوپ یک میکروسکوپ کاغذی است که با تا کردن[بیشتر بخوانید]
محیط کشت VRBA (ویولت رد بایل آگار): ترکیب، اصول، آمادهسازی، نتایج و موارد استفاده
مقدمهای بر محیط کشت VRBA کلیفرمها (Coliform) به تمام باکتریهای میلهای شکل هوازی و اختیاری[بیشتر بخوانید]
4 دیدگاه
محیط کشت CIN یا یرسینیا: اصول، ترکیب، روش آمادهسازی و موارد استفاده
محیط کشت CIN یا یرسینیا چیست؟ سفسولودین- ایرگاسان- نووبیوسین آگار (Cefsulodin-Irgasan-Novobiocin Agar (CIN Agar)) که[بیشتر بخوانید]
محیط انتقال آمیس ترانسپورت (Amies Transport Medium): ترکیب، اصول، آمادهسازی، نتایج و موارد استفاده
محیط انتقال آمیس ترانسپورت چیست؟ محیط انتقال آمیس ترانسپورت یک محیط انتقال بهبود یافته است[بیشتر بخوانید]
مارتین لوئیس آگار (Martin Lewis Agar): ترکیب، اصول، روش آمادهسازی، نتایج و موارد استفاده
مقدمهای بر مارتین لوئیس آگار تایر مارتین آگار (Thayer Martin Agar) در سال 1964 برای[بیشتر بخوانید]
تفاوت بین ژل آگارز و پلی اکریل آمید چیست؟
تفاوت بین ژل آگارز و پلی اکریل آمید به صورت عمده وجود دارد که منجر[بیشتر بخوانید]
پپتون واتر (Peptone Water): ترکیب، اصول، روش آمادهسازی، نتایج و موارد استفاده
پپتون واتر توسط Shread، Donovan و Lee فرموله شده است. این محیط یک محیط براث[بیشتر بخوانید]
6 دیدگاه